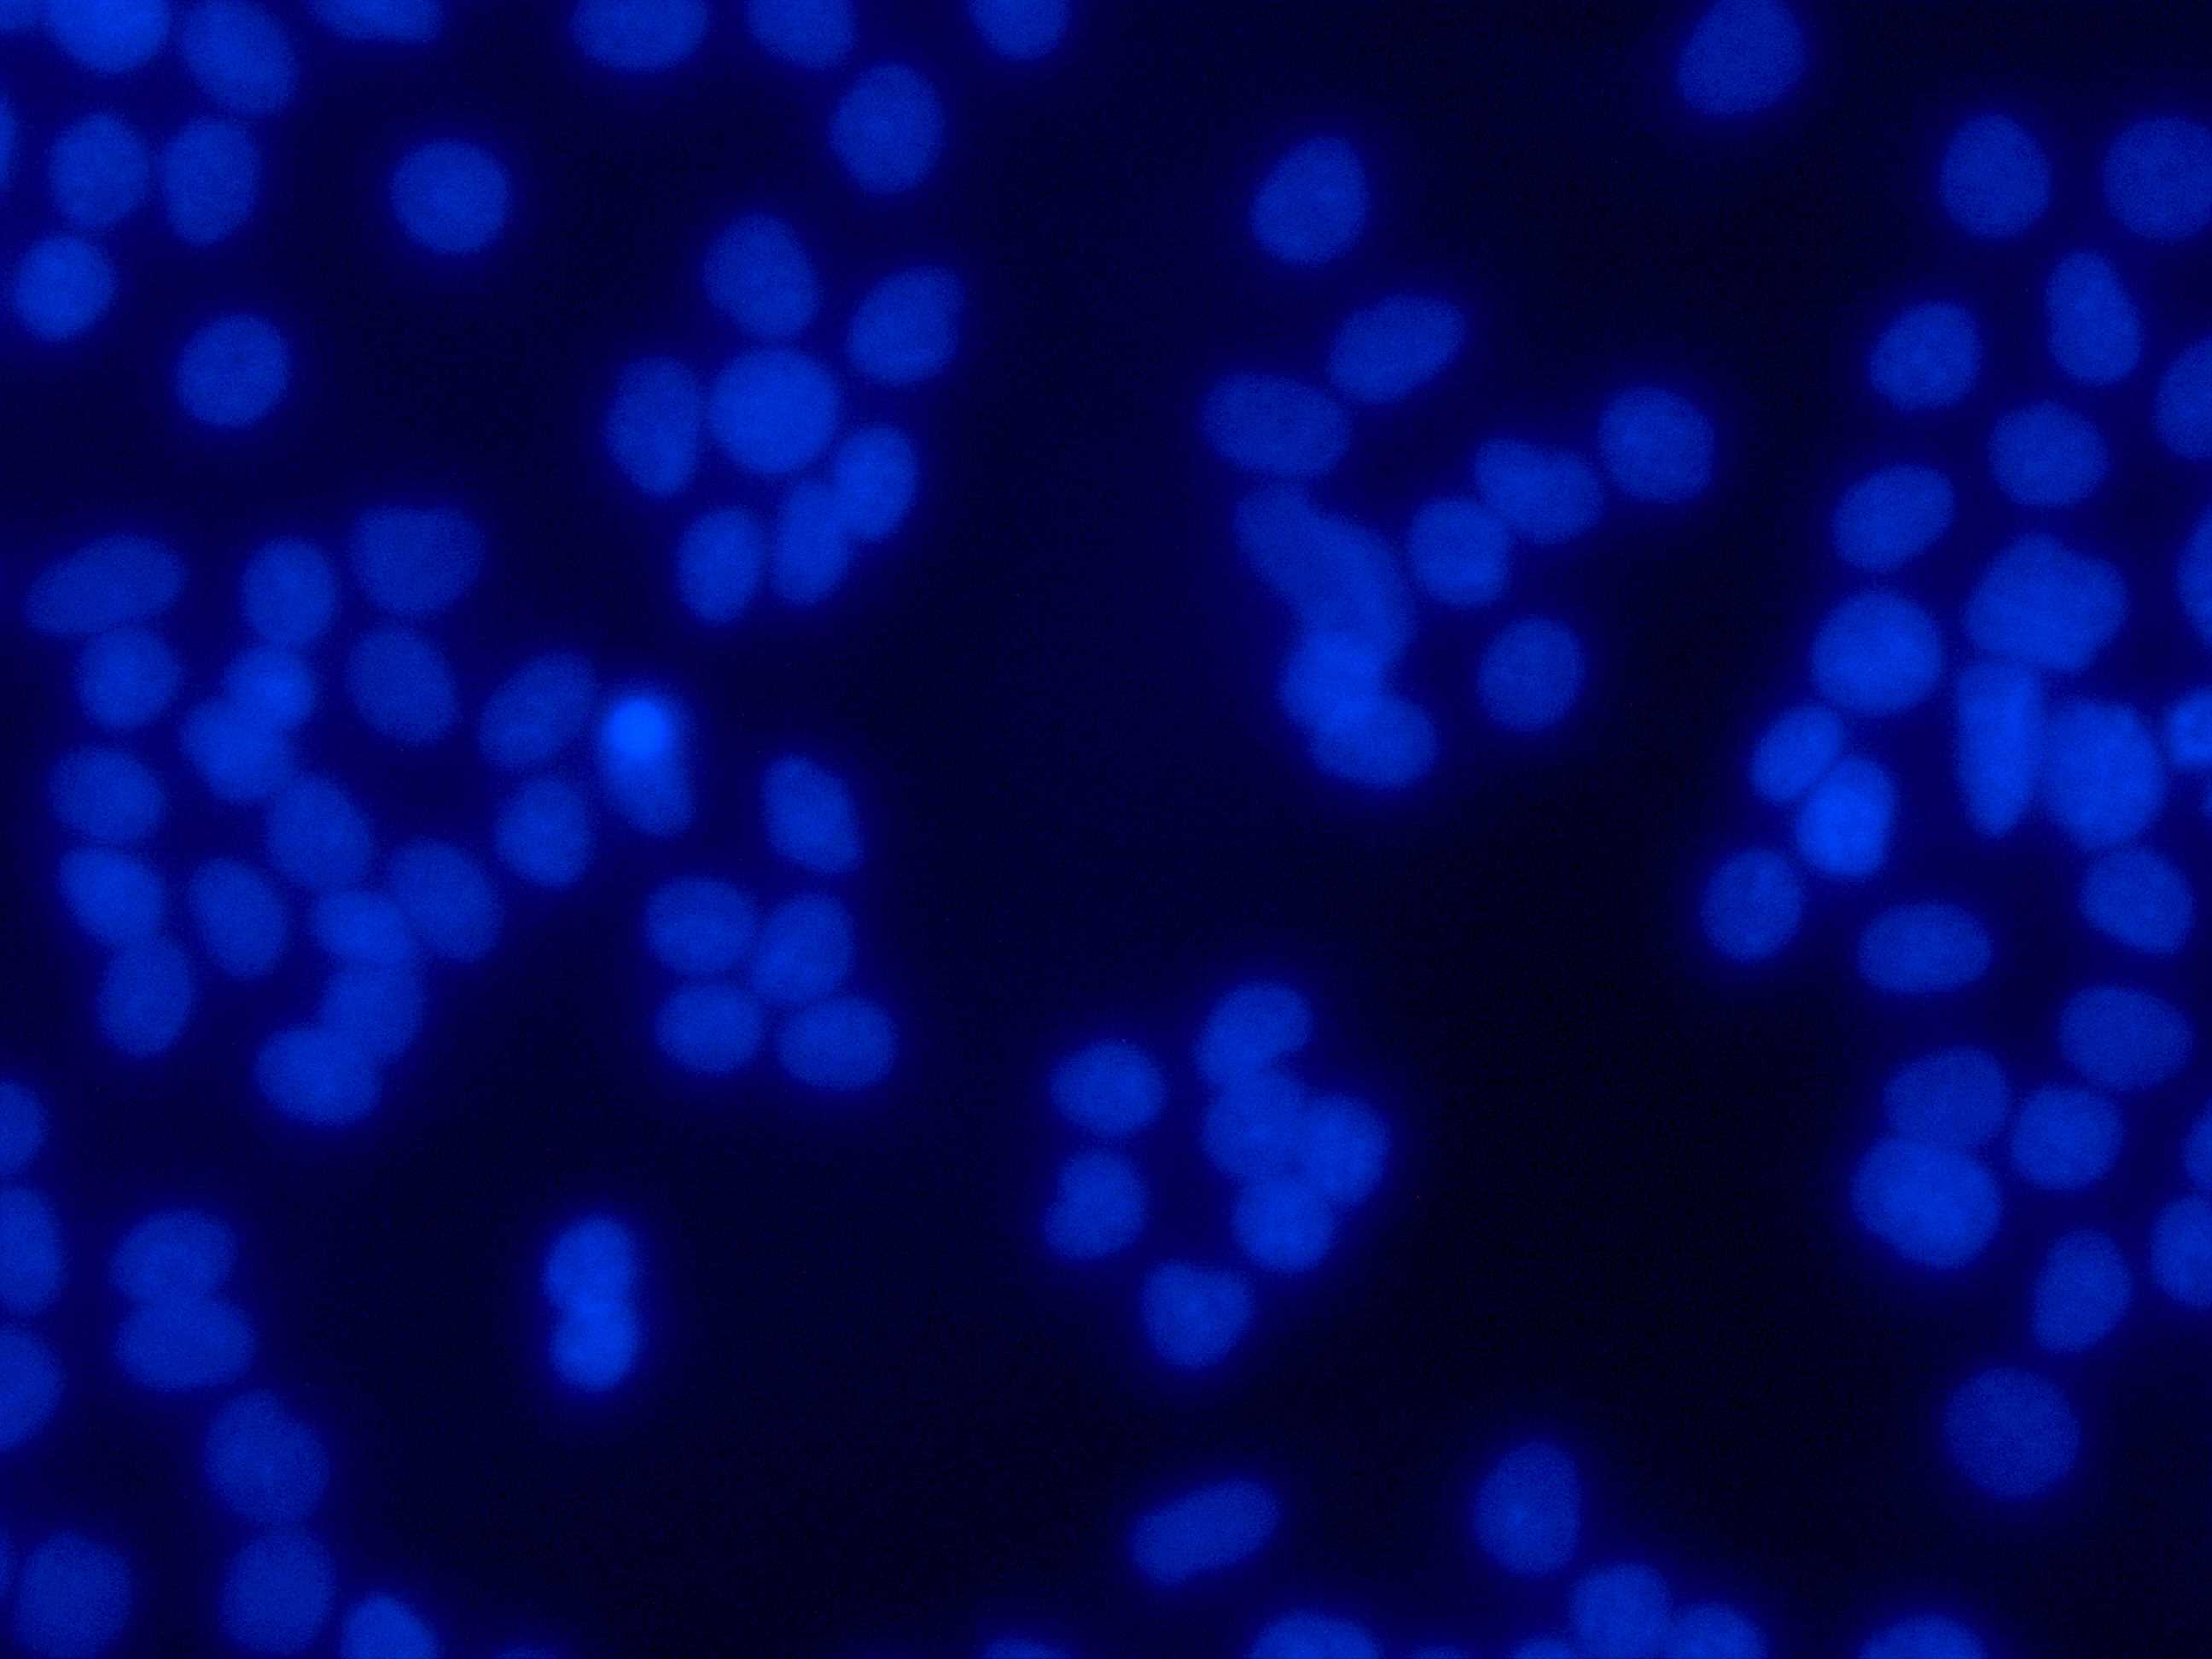
MCF 7

If you are having a hard time accessing the Atcc Mcf7 page, Our website will help you. Find the right page for you to go to Atcc Mcf7 down below. Our website provides the right place for Atcc Mcf7.

https://www.ufficiocamerale.it › mare-engineering-spa
Se desideri offuscare parte delle informazioni es indirizzo sede legale procedi con il form seguente Il form pu essere compilato unicamente dal titolare della persona giuridica interessata

https://www.milanofinanza.it › news › mare-group-storia-e-numeri-dell...
Ma qual il business nel quale si muove Mare Group Quello dell ingegneria digitale ovviamente un settore ad alto grado di innovazione con ambiti di applicazione in tutto il mondo tech

https://it.linkedin.com › company › maregroup
Mare Group una societ di ingegneria che promuove l innovazione per le imprese di ogni dimensione attraverso le tecnologie abilitanti concentrandosi sulla trasformazione digitale e sulla

https://finanza.repubblica.it › News › mare_group_conclusa_con...
Si tratta della prima volta dalla nascita di Eles che un azionista supera la soglia detenuta dal fondatore Mare Group diventa il primo azionista della societ realizzando pienamente

https://www.websim.it › notizie › small-mid-cap › notizie › mare-il-gioiello...
Mare d la possibilit di abilitare nuove tecnologie di ingegneria digitale e formare il personale Il gruppo nato nel 2001 in seno all Universit Federico II di Napoli con un impostazione

https://www.wallstreetitalia.com › mare-group-con-la-sia-ed-eles...
Che futuro vede per Mare Group Saremo un gruppo europeo ma radicato in Italia con un ruolo centrale nei grandi programmi industriali dalla difesa alla manifattura avanzata dalle
https://bebeez.it › private-equity
Venerd 12 dicembre Mare Group gruppo campano della componentistica aerospaziale quotato all Euronext Growth Milan ha infatti comunicato di avere superato la soglia del 30 del

https://forbes.it
Oggi alla guida di Mare Group una holding che vanta una presenza su tutto il territorio nazionale e un espansione su scala internazionale Negli anni ha sviluppato tecnologie abilitanti

https://finanza.lastampa.it › News › mare-group-il-ceo-scrive-agli-azionisti-di...
Questo ecosistema conta al 31 12 2024 aggregando Mare Group e La Sia un volume d affari di oltre 60 milioni di euro con un EBITDA margin superiore al 20 pi di 500 professionisti
Thank you for visiting this page to find the login page of Atcc Mcf7 here. Hope you find what you are looking for!